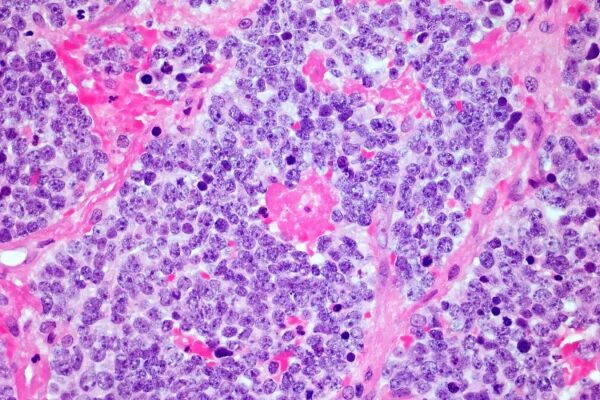
Терапия CAR T-клетками может замедлить развитие нейродегенеративных заболеваний, таких как боковой амиотрофический склероз (БАС). 3 3605051f69cd104e42fb01e482285901

Иммунные клетки головного мозга, вышедшие из-под контроля, способствуют гибели нейронов, поэтому их удаление может замедлить прогрессирование нейродегенеративных заболеваний, таких как боковой амиотрофический склероз.
Иллюстрация CAR T-клеточной терапии (зеленый цвет), атакующей раковую клетку (розовый цвет). НЕМЕС ЛАСЛО/ФОТОБИБЛИОТЕКА НАУКИ
Генетически модифицированные иммунные клетки, известные как CAR-T-клетки, могут замедлить прогрессирование нейродегенеративного заболевания — бокового амиотрофического склероза (БАС) — путем уничтожения патологических иммунных клеток в головном мозге.
«Это не способ вылечить болезнь, — говорит Давиде Тротти из Центра лечения БАС им. Джефферсона Вайнберга в Пенсильвании. — Цель — замедлить развитие болезни».
По словам Тротти, средняя продолжительность жизни людей с диагнозом БАС составляет всего от двух до пяти лет, поэтому замедление прогрессирования заболевания имело бы огромное значение. Возможно, такой же подход мог бы помочь замедлить развитие и других нейродегенеративных заболеваний.
Боковой амиотрофический склероз (БАС), также известный как болезнь Лу Герига, вызывается потерей двигательных нейронов — нервных клеток, контролирующих произвольные мышцы. Физик Стивен Хокинг страдал БАС, но его случай был исключительным, поскольку он прожил очень долго. Менее 10 процентов людей, у которых диагностировано это заболевание, живут более десяти лет.
Тротти отмечает, что в разработке методов лечения форм БАС, вызванных генетическими мутациями, достигнут определенный прогресс, но на них приходится лишь 5-10 процентов случаев. Для спорадических форм БАС, причины которых неизвестны, методов лечения не существует.

Однако существуют доказательства того, что воспаление в головном мозге способствует гибели двигательных нейронов. В частности, некоторые иммунные клетки, известные как микроглия, по-видимому, переходят в состояние повышенной активности.
Микроглия обычно защищает мозг от инфекций, очищает его от мусора и помогает удалять лишние связи, или синапсы, между нейронами. Но если некоторые из них становятся чрезмерно активными, они могут удалить слишком много синапсов и способствовать гибели нейронов. «Они выходят из-под контроля», — говорит Тротти.
В серии экспериментов, включавших изучение тканей головного и спинного мозга людей с БАС, команда Тротти показала, что эти микроглиальные клетки, усиливающие повреждения, как их называют, имеют множество выступающих из своей поверхности белков под названием uPAR. «Таким образом, они помечены, и, зная эту метку, мы можем воздействовать на них и удалять их из центральной нервной системы», — говорит Тротти.
Для этого его команда обратилась к CAR-T-клеткам — иммунным клеткам, генетически модифицированным для уничтожения клеток со специфическими белками на поверхности. CAR-T-клетки оказались очень эффективными в лечении некоторых видов рака и в настоящее время проходят испытания для лечения гораздо более широкого спектра заболеваний, таких как аутоиммунное заболевание — волчанка.
В ходе исследований клеток, растущих в культуре, команда показала, что CAR-T-клетки, нацеленные на uPAR, могут уничтожать дефектные микроглиальные клетки, не повреждая нейроны. Таким образом, хотя это лечение не может заменить утраченные двигательные нейроны, есть надежда, что оно значительно замедлит дальнейшую гибель клеток.
В настоящее время проводятся испытания на мышах с мутацией, вызывающей у них одну из форм БАС (бокового амиотрофического склероза), результаты которых ожидаются примерно через год. Серьезность БАС и отсутствие методов лечения означают, что регулирующие органы могут помочь ускорить испытания на людях, если эти результаты окажутся многообещающими.
CAR T-клетки обеспечивают рекордную 18-летнюю ремиссию рака нервной системы.
У человека с нейробластомой, заболеванием, при котором развивающиеся нервные клетки у детей превращаются в злокачественные, благодаря терапии CAR T-клетками уже более 18 лет нет опухоли.
«Доказательства иммунной дисфункции при БАС накапливаются», — говорит Аммар Аль-Шалаби из Королевского колледжа Лондона, чья команда тестировала иммунотерапию при БАС. «Мне это кажется очень многообещающим и интересным подходом».
Вполне вероятно, что микроглия, усиливающая повреждения, также способствует развитию других нейродегенеративных заболеваний, возможно, включая некоторые виды деменции, поэтому это лечение может найти более широкое применение за пределами БАС. «Это может стать способом замедления развития подобных нейродегенеративных заболеваний», — говорит Тротти.
У CAR-T-клеток есть ряд существенных недостатков в качестве терапии: они могут вызывать серьезные побочные эффекты, и, поскольку они обычно получают из собственных клеток пациента, их производство очень дорого. Однако многие группы исследователей по всему миру работают над способами сделать их более безопасными и дешевыми, например, путем генерации клеток внутри организма, чтобы не требовалось их извлечение.
bioRxiv DOI: 10.64898/2025.12.29.696307
Реклама
Подпишитесь на нашу еженедельную рассылку.
Зарегистрироваться
Источник: www.newscientist.com
























